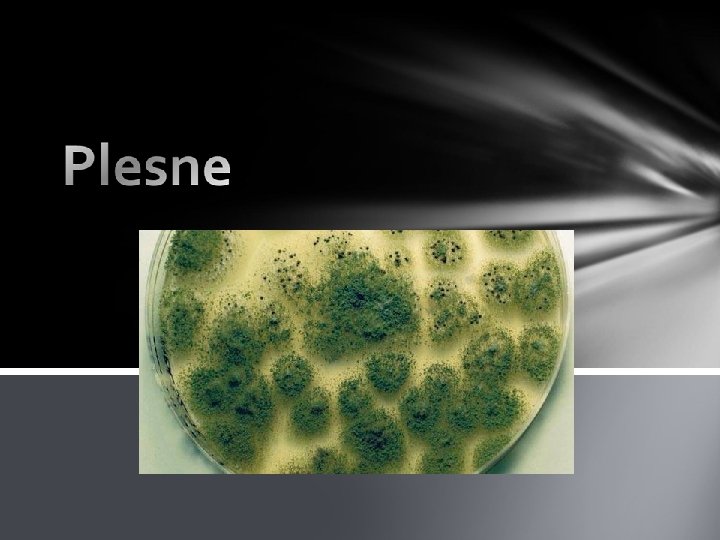

Pomcky igelitov vreck 4 kusy 6 kskov chleba

Pomôcky: igelitové vrecká (4 kusy) 6 kúskov chleba Úloha: Zistiť , v ktorom prostredí sa najrýchlejšie vytvorí pleseň na chlebe. Chladnička Čas: 3 týždne Cieľ: Zistiť aké sú navhodnejšie podmienky pre vytvorenie plesní.

Postup: 1. Pripravíme si 6 kúskov chleba. Dva namočíme do vody a potom ich vložíme do igelitových vrecúšok (každý zvlášť). Dva dáme len tak do vrecúšok a dva kúsky necháme tak. 2. Z každej dvojice vyberieme jeden a dáme ho do chladničky. 3. Pozorujeme všetky kúsky 3 týždne.

1. Týžden Pleseň sa začala vytvárať len na chlebe, ktorý bol vo vrecku pri izbovej teplote. Ostatné chleby boli nezmenené.

2. Týždeň Mokrý chlieb je už celý splesnený. Začínajúca pleseň je aj na suchom chlebe, ktorý je v sáčku a nie je v chladničke. Ostatné chleby sú stále rovnaké.

3. Týždeň Skoro celý splesnený je chlieb, ktorý bol v mokrý vo vrecku a v chladničke. Mokrý chlieb mimo chladničky: Chlieb vo vrecku je takmer celý splesnený. Začína plesnieť aj suchý chlieb Vo vrecku, ktorý je v chladničke. Chleby, ktoré neboli vo vrecku nie sú vôbec splesnené.

Záver: Zistila som, že pleseň sa najskôr vytvorí na chlebe, ktorý je mokrý vo vrecku a pri izbovej teplote. Sú to najvhodnejšie podmienky pre vytvorenie plesní. Kormančíková 2. A
- Slides: 7